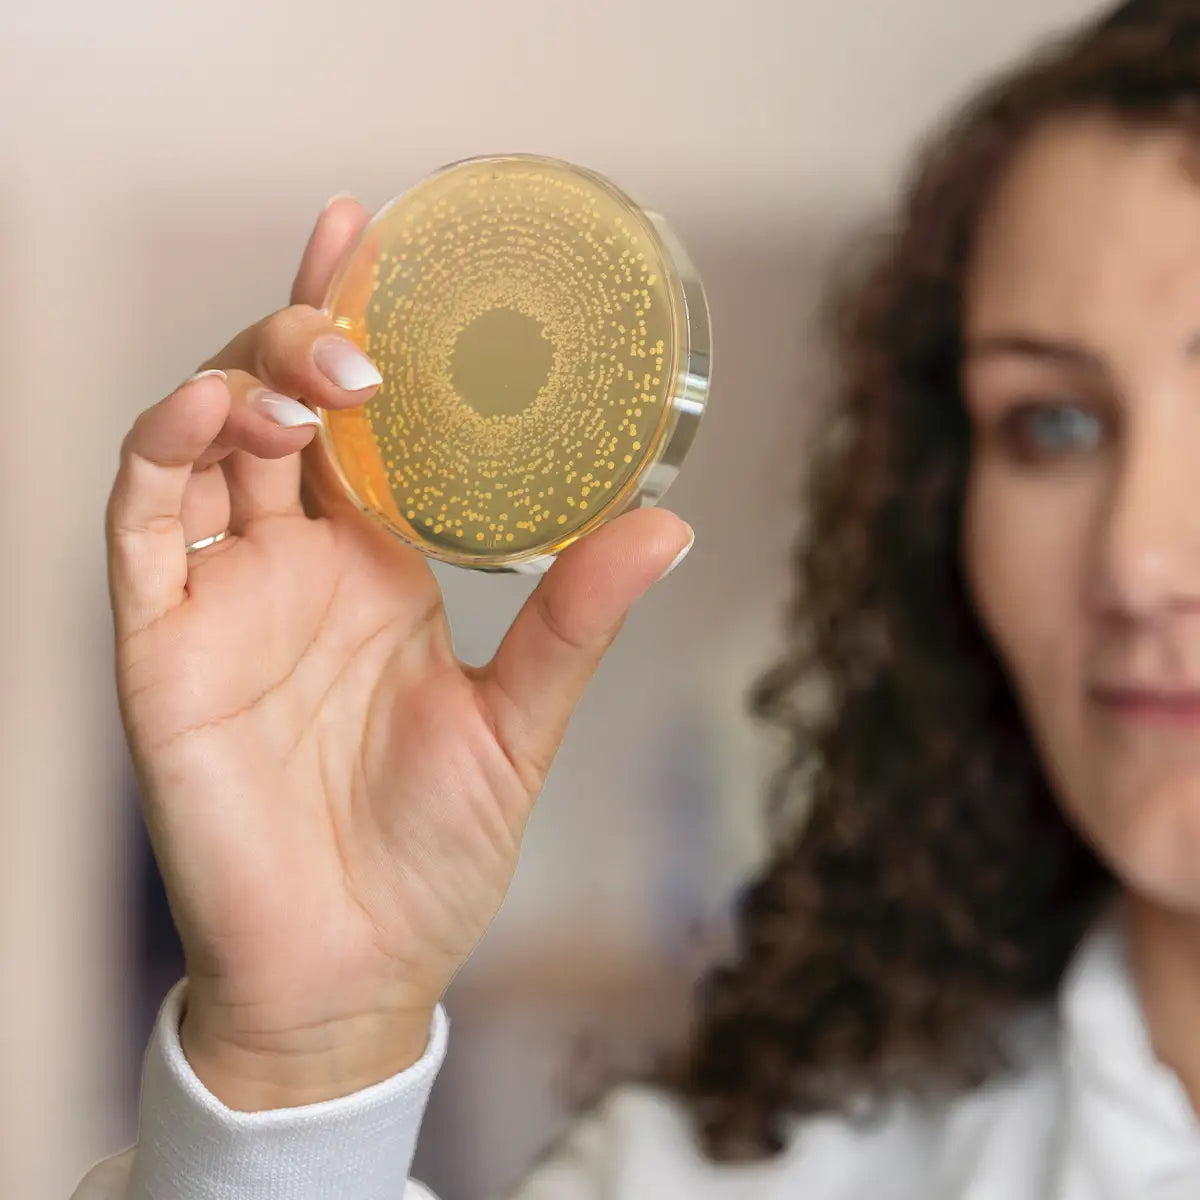
Eine Wissenschaftlerin hält eine Petrischale mit Bakterienkulturen (L. reuteri Prodentis) in die Kamera, um die wissenschaftliche Forschung zu verdeutlichen.

BiGaia® Prodentis® FRESH BREATH
Nahrungsergänzungsmittel für den Mund*
Warum gerade dieses Nahrungsergänzungsmittel?
JETZT IN IHRER APOTHEKE KAUFEN
BioGaia ist einer der weltweiten Marktführer im Bereich von Nahrungsergänzungsmittel

Was ist SelectBiotics™?
FAQ